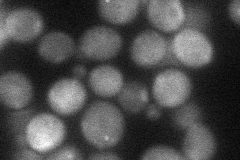

View description
Mitochondrial porin (voltage-dependent anion channel), outer membrane protein required for the maintenance of mitochondrial osmotic stability and mitochondrial membrane permeability; phosphorylated
Localization:
Intensity:
Fold change:
Significance:
-
C’ GFP library in SD

mitochondria83.02 -
N' NOP1pr-GFP in SD

cytosol,punctate186.827 -
N' TEF2pr-mCherry in SD
punctate32.247 -
N' NATIVEpr-GFP in SD

missing0 -
N' TEF2pr-VC and Cyto-VN in SD

mitochondria39.4137 -
C’ GFP library in SD+DTT

mitochondria66.470.8No -
C’ GFP library in SD+H2O2

mitochondria63.740.76No -
C’ GFP library in Starvation Media

mitochondria85.031.02No -
C’ GFP library on the background of Pup2-DaMP

mitochondria -
C’ GFP library on the background of CCT mutant

mitochondria46.46250.559621Yes
